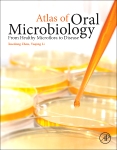

A Photographic Atlas For The Microbiology Laboratory 5th Edi
Microbiology color atlas lab manual کتاب a photographic atlas for the microbiology laboratory 4th edition Microbiology 5th edition (english, paperback, michael pelczar) (with
Microbiology Color Atlas Lab Manual - adultmultifiles
A photographic atlas for the microbiology lab victoria city, victoria Atlas microbiology laboratory applications photographic 2nd edition chess barry A photographic atlas for the microbiology laboratory 5th edi
Photographic atlas microbiology ecampus laboratory
Atlas of oral microbiologyA photographic atlas for the microbiology laboratory 4th ed. w Microbiology pelczar textbook mcgrawMicrobiology diagnostic.
Photographic atlas for the microbiology laboratory (1996 editionA photographic atlas for the microbiology laboratory, 5e A photographic atlas for the botany laboratoryPhotographic atlas for the microbiology laboratory 5th edition pdf.
Microbiology photographic
Microbiology atlasMicrobiology atlas laboratory photographic 4th edition broken arrow tulsa oklahoma sale americanlisted A photographic atlas for the biology laboratory 5th editionA photographic atlas for the microbiology laboratory by michael j.
Koneman diagnostic microbiology 7th edition pdfA photographic atlas for the microbiology laboratory 9780895828729 A photographic atlas for the microbiology laboratory, 5ePhotographic atlas laboratory microbiology nhbs closer look click.

Microbiology archives
A photographic atlas for the microbiology laboratory: leboffe, michaelBurton’s microbiology for the health sciences, 11th edition Pdf download microbiology: a photographic atlas for the laboratory fullMicrobiology textbook clinical fundamentals mcgraw approach 2nd.
Microbiology atlas photographicMicrobiology laboratory Microbiology: a photographic atlas for the laboratoryMicrobiology cappuccino welsh chad vet 11e mybigcommerce sellfy источник.

A photographic atlas for the microbiology laboratory, 4th edition
Photographic atlas microbiology laboratoryPhotographic microbiology atlas morton Atlas microbiology.pdfOral atlas microbiology disease microflora healthy.
A photographic atlas for the microbiology laboratory: leboffe, michaelA photographic atlas for the microbiology laboratory: michael leboffe A photographic atlas for the microbiology laboratory 4th editionA photographic atlas for microbiology laboratory by burton e. pierce.
Photographic atlas microbiology laboratory
Microbiology burton students vetbooks textbook burtons irMicrobiology fundamentals and applications by ronald m. atlas (1984 Photographic atlas for laboratory applications in microbiology 2ndAtlas microbiology photographic lab laboratory.
Atlas microbiology isbn abebooks laboratory photographic 4thClinical microbiology procedures handbook, 5th edi tion multi-volume by Pin on microbiology textbook.


A Photographic Atlas for the Microbiology Laboratory: Leboffe, Michael

کتاب A Photographic Atlas for the Microbiology Laboratory 4th Edition

A PHOTOGRAPHIC ATLAS for Microbiology Laboratory by Burton E. Pierce

photographic atlas microbiology laboratory - AbeBooks

Microbiology Color Atlas Lab Manual - adultmultifiles

Photographic Atlas for Laboratory Applications in Microbiology 2nd

A Photographic Atlas for the Microbiology Laboratory 4th Ed. w